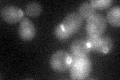
YBL061C
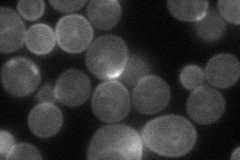
YBL061C

View description
Activator of Chs3p (chitin synthase III), recruits Chs3p to the bud neck via interaction with Bni4p; has similarity to Shc1p, which activates Chs3p during sporulation
Localization:
Intensity:
Fold change:
Significance:
-
C’ GFP library in SD
bud neckN/A -
N' NOP1pr-GFP in SD
bud neck56.0979 -
N' TEF2pr-mCherry in SD

cell periphery,bud66.6665 -
N' NATIVEpr-GFP in SD

bud neck24.0893 -
N' TEF2pr-VC and Cyto-VN in SD

cell periphery,punctate37.9434 -
C’ GFP library in SD+DTT

bud neckN/AN/ANo -
C’ GFP library in SD+H2O2

cytosol25.94N/ANo -
C’ GFP library in Starvation Media

bud neck18.30.62Yes -
C’ GFP library on the background of Pup2-DaMP

bud neck -
C’ GFP library on the background of CCT mutant

bud neck22.96640.782027No
